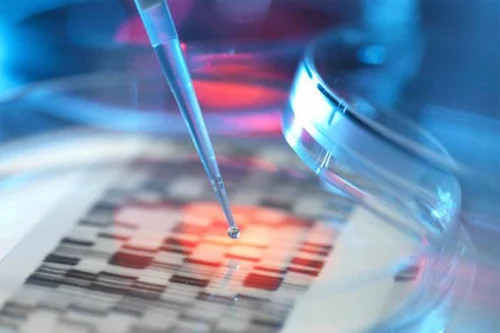
c23.webp

拉肚子可以吃猪肝吗 猪肝的营养价值
猪肝的营养价值是非常高的,所以还是有非常多喜爱的人群,但是人食五谷杂粮,难免会有生病不舒服的时候,尤其是在夏季,肠胃经常也会犯病,拉肚子相信也是很多人经历的事情,那么在拉肚子的时候,大家能不能吃猪肝呢?
4、猪肝的营养价值
猪肝中含有丰富的维生素A,大家都知道维生素A的功效就是能保护眼睛,维持正常视力,防止眼睛干涩、疲劳,另外还可以维持健康的肤色,对皮肤的健美具有重要意义。因此,需长期面对电脑工作的妈妈们,或者想改善脸色暗黄的妈妈,可以选择食用猪肝食谱,猪肝粥就是个不错的选择。
相关内容
葫芦瓜的营养作用与功效与作用(葫芦瓜的营养和功效)
1. 葫芦瓜的营养和功效,2. 葫芦瓜的营养和功效与作用,3. 葫芦瓜的营养功效与作用,4. 葫芦瓜的营养和功效与禁忌,5. 葫芦瓜的营养和功效作用,6. 葫芦瓜有什么营养价值也请读出来,7. 葫芦瓜的功效与作用及食用方法,8. 葫芦瓜的营养价值和功效,9. 葫芦瓜有什么营养和功效,10. 葫芦瓜的药用价值与功效,葫芦瓜,营养,功效,功效与作用,作用,1. 葫芦瓜的营养和功效葫瓜不是葫芦瓜,葫芦瓜一般指的是瓠子,葫芦瓜指的是葫芦科葫芦属一年...
车厘子的作用与营养(车厘子功效和营养)
1. 车厘子功效和营养,2. 车厘子营养与功效,3. 车厘子功效和营养功效区别,4. 车厘子功效和营养价值,5. 车厘子有什么功效与营养,6. 车厘子的功效,7. 车厘子功效营养价值,8. 车厘子的营养及功效,9. 车厘子的功效和营养,10. 车厘子的营养价值与功效苹果绿,功效,营养,营养价值,作用,苹果绿,1. 车厘子功效和营养它营养价值高,坚持食用有很大的功效,车厘子具有促进消化、健脾和胃、美容养颜的作用。车厘子含有大量的营养物质,如花...
革命菜图片功效作用(革命菜的功效和作用主治)
1. 革命菜的功效和作用主治,2. 革命菜的功效和作用主治与用量,3. 革命菜有什么功效,4. 革命菜的营养价值,5. 革命菜百科,6. 革命菜的功效和作用主治与禁忌,7. 革命菜的功效与副作用,8. 革命菜的药用价值,9. 革命菜的功效和作用主治是什么,10. 革命莱的功效与作用,11. 革命菜是什么菜,功效,作用,主治,用量,副作用,1. 革命菜的功效和作用主治蒿菜的种类有:艾蒿、茼蒿、芦蒿、牡蒿、青蒿和香蒿。蒿菜的用途有:1、蒿菜中含...
猪舌的营养价值以及功效与作用(猪舌的营养价值以及功
1. 猪舌的营养价值以及功效与作用是什么,2. 猪舌的营养和功效,3. 猪舌的营养价值和功效,4. 猪舌 功效,5. 猪舌有什么功效与作用,6. 猪舌的功效与作用、禁忌和食用方法,7. 猪舌有没有营养,8. 猪舌的营养价值以及功效与作用是什么呢,9. 猪舌的好处和坏处,10. 猪舌又名什么,猪舌,功效与作用,营养价值,营养,功效,1. 猪舌的营养价值以及功效与作用是什么猪舌头的热量相对来说比较高,每100克猪舌头中含有230大卡左右的热量。...
黄瓜的营养成分的作用(黄瓜的营养成分功效和作用)
1. 黄瓜的营养成分功效和作用,2. 黄瓜的营养价值与药用价值,3. 黄瓜的营养成分与功效,4. 黄瓜的营养成分功效和作用及禁忌,5. 黄瓜的营养成分及作用,6. 黄瓜的营养成分功效和作用是什么,7. 黄瓜的营养成分和对人体的作用,8. 黄瓜营养价值及功效表,9. 黄瓜的营养成分和功效有哪些,黄瓜,营养成分,作用,功效,营养价值,1. 黄瓜的营养成分功效和作用黄瓜营养表(100克) 水份 96.5克 热量 12.5千卡 蛋白质 0.6克 脂...
马面鱼的功效与作用及禁忌
马面鱼的功效与作用及禁忌,面鱼,多种,疾病,营养价值,功效与作用,可治,疗效,产后,功能效用马面鱼是一种温暖性近底层鱼类,马面鱼无毒,含有蛋白质、维生素及脂肪等营养成分,马面鱼营养价值不比其它鱼类差,是一种物美价廉的食用鱼类。具有治疗多种疾病、补充氨基酸、通乳等作用。1.治疗多种疾病马面鱼可治胃病、乳腺炎、消化道出血等多种疾病。2.补充氨基酸马面鱼含有丰富的蛋白质及多种氨基酸,可为人体补充氨基酸及营养物质。3.通乳马面鱼与木瓜搭配煮汤,对产...
蛤蜊汤的功效与作用及禁忌
蛤蜊汤的功效与作用及禁忌,蛤蜊汤,预防,蛤蜊,消肿,功效,海鲜汤,铁元素,营养价值,功能效用蛤蜊汤,是一道营养鲜美的海鲜汤,主要材料为蛤蜊、蔬菜,由新鲜蛤蜊及其他新鲜蔬菜熬制而成,蛤蜊为主、蔬菜为辅,营养价值极高。具有止咳化痰、利尿消肿、预防贫血等功效。1.止咳化痰,利尿消肿蛤蜊汤中含有非常高的碘元素,对治疗人体的甲状腺肿大很有益处。蛤蜊性质平和,有一定的止咳化痰的功效,且能促进身体的新陈代谢,具有利尿消肿的功效。2.预防贫血蛤蜊汤中含有铁...
荞头的功效与作用及禁忌
荞头的功效与作用及禁忌,荞头,食欲,强健,体温,筋骨,营养价值,成分,功效与作用,功能效用荞头又叫藠头,属百合科多年生宿根性草本植物。鳞茎球形,似洋葱,白色,是主要的食用部分。荞头味辛,性温,具有增进食欲、治疗疾病、提高体温、强健筋骨的功效。1.增进食欲荞头含烯丙基硫醚,这种物质会刺激胃液的分泌,有助于食欲的增进,还可以刺激肠胃功能的提高。2.治疗疾病荞头被誉为“菜中灵芝”,对中医而言,荞头所含的许多成分对冠心病、心绞痛、胃神经官能症、肠胃...
玛咖粉的功效与作用及禁忌
玛咖粉的功效与作用及禁忌,玛咖粉,受孕,多种,玛咖,抗疲劳,成分,营养价值,碱能,功能效用玛咖粉以玛咖为原料,经切片、干燥、粉碎、灭菌等步骤制成,呈淡黄色粉末状,含有多种生物碱活性成分、介子油苷、甾醇、多种氨基酸等营养物质。具有抗疲劳、调节内分泌系统、对抗更年期综合征、增加受孕能力和受孕机会的功效。1.抗疲劳玛咖粉中氨基酸、矿物质锌、牛磺酸等成分能明显对抗疲劳。2.调节内分泌系统玛咖粉中的多种生物碱作用于下丘脑和脑垂体,调节肾上腺、胰腺、睾...
野酸枣的功效与作用及禁忌
野酸枣的功效与作用及禁忌,野酸枣,预防,胆结石,益气,果酸,营养价值,功效,营养,功能效用野酸枣为酸枣树的果实,野酸枣除了是一种营养丰富的水果之外,它还是治疗神经衰弱、失眠、多梦、盗汗的食疗佳品,具有补充营养、益气健脾、预防胆结石和骨质疏松的功效。1.补充营养野酸枣虽然是一种野生水果,但营养价值特别高,含有丰富的多糖、果酸、微量元素和胡萝卜素,食用以后野酸枣的营养可以为人体所用,促进身体代谢,增强身体素质。2.益气健脾野酸枣是一种能补中益气...
野米的功效与作用及禁忌
野米的功效与作用及禁忌,野米,增强体质,营养价值,功效,补充营养,滋阴补肾,膳食纤维,食材,功能效用野米称为“黑珍珠”,又称冰湖野米,其色泽黑亮,形似木梭状,煮粥、炖汤口味尤佳。野米与稻米是两种不同的食材,是一种禾本科菰的种子,外壳不用打磨,呈灰黑颜色,含有较高的营养成分。野米中的蛋白质、微量元素、膳食纤维比大米高的多,是难得的保健食物,可称之为“米”中之王。具有增强体质、补充营养、滋阴补肾的功效。1.增强体质天然的野米颜色黑亮,具有排毒、...
炒紫苏子的功效与作用及禁忌
炒紫苏子的功效与作用及禁忌,止咳,化痰,降气,营养价值,紫苏,功效,功效与作用,胸膈,功能效用炒紫苏子是一种常见的中药,为唇形科植物紫苏的干燥成熟果实。秋季果实成熟时采收,除去杂质,晒干,压碎有香气,味微辛。炒紫苏子是经过炒制后制成的,临床还可以做成蜜炙紫苏子、紫苏子霜。炒紫苏子相对于紫苏子的药性有所缓和,具有降气化痰、止咳平喘、润肠通便的功效。1.降气化痰、止咳平喘炒紫苏子具有降气化痰、止咳平喘的功效,可下气消痰,用于痰盛咳喘、胸膈满闷导...
柴鱼的功效与作用及禁忌
柴鱼的功效与作用及禁忌,柴鱼,作用,益胃,预防,功效与作用,消肿,功效,营养价值,功能效用柴鱼是冷水性鱼类鳕鱼的干燥制品,由于长得像柴而被称之为“柴鱼”。最大的特点是宜于长久贮藏,可保存三年不坏,用其做汤,味道甚佳。柴鱼含有丰富的脂肪、蛋白质、氨基酸、多种微量元素以及矿物质,具有化痰止咳、健脾益胃、预防高血压、利尿消肿等功效。1.化痰止咳柴鱼对咽喉部有良好的湿润和物理治疗作用,有利于治愈局部炎症,并能解除局部痒感,阻断咳嗽反射。2.健脾益胃...
狗爪豆的功效与作用及禁忌
狗爪豆的功效与作用及禁忌,狗爪豆,功效,作用,帕金森,治疗,预防,功效与作用,营养价值,功能效用狗爪豆是缠绕藤本植物,其种子和叶子可入药。一般于秋季采收,打下种子后,将枝叶和种子晾干。枝叶晾干呈黄绿色,种子呈棕黑色,具有治疗腰脊酸痛、预防帕金森、降压的功效。1.治疗腰肌酸痛狗爪豆具有温中益气的功效,服用后可调理机体气脉,具有治疗腰肌酸痛的功效和作用。2.预防帕金森狗爪豆中含有左旋多巴,左旋多巴可以作用于黑质多巴胺神经元,起到预防帕金森的作用...
鲜枣子的功效与作用及禁忌
鲜枣子的功效与作用及禁忌,枣子,营养价值,肝脏,防治,使血,功效与作用,富含,枣果,功能效用鲜枣子又名鲜食枣,是指没有经过加工直接从枣树采摘下来的枣果。鲜枣子的营养价值比干制枣类营养价值高很多,但由于保鲜技术缺陷,导致不利于保存。所以鲜枣子的保鲜期比较短暂,建议即摘即食。鲜枣子具有保护肝脏、防治心脑血管疾病、降低血压的作用。1.保护肝脏鲜枣子的维生素C含量远比晒干制成的枣果中维生素C的含量要高。维生素C可以促进人体蛋白质的合成,使血清总蛋白...
金针花的功效与作用及禁忌
金针花的功效与作用及禁忌,金针花,补虚,营养价值,功效,下奶,碳水化合物,膳食纤维,保护皮肤,功能效用金针花又名黄花、黄花草、忘忧草、七星菜、安神菜,属百合科多年生草本植物,具有“观为花、食为菜、用为药”的美称。其中的胡萝卜素含量不亚于胡萝卜,花味清香,既可以食用,也可以药用,营养价值比较高,富含卵磷脂、蛋白质、碳水化合物、膳食纤维和多种维生素,具有健脑、补虚下奶、保护皮肤等功效。1.健脑金针花中含有丰富的卵磷脂,是大脑细胞的重要组成成分,...
红薯头的功效与作用及禁忌
红薯头的功效与作用及禁忌,红薯,预防,作用,通便,营养价值,营养,膳食纤维,头能,功能效用红薯头有很多的营养价值,因为它含有很多的粗纤维,对于促进肠胃的蠕动以及消化是很好的,而且其中的淀粉是可以充当主食填充肚子。具有通便减肥、抗衰老、预防心血管疾病的功效。1.通便减肥吃红薯头能有效地阻止糖类变为脂肪,有利于减肥、健美。红薯头含有大量膳食纤维,在肠道内无法被消化吸收,能刺激肠道,增强蠕动,通便排毒,尤其对老年性便秘有较好的疗效。2.抗衰老红薯...
吊瓜的功效与作用及禁忌
吊瓜的功效与作用及禁忌,吊瓜,利气,治疗,作用,心脑血管,多种,营养价值,功效,功能效用吊瓜又名栝楼、瓜蒌、糖瓜蒌、蒌瓜,为葫芦科多年生草质藤本植物,其味脆、润绵爽口。皮、籽、根均可入药,具有清热化痰、利气宽胸、润肠通便、抑菌、保护心脑血管等功效。1.清热化痰吊瓜甘寒清润,可以清肺热、润肺燥而化热痰、燥痰,治疗肺热咳嗽、痰浊黄稠或者燥热伤肺、干咳少痰的效果非常好。从吊瓜中分离得到的氨基酸具有良好的祛痰效果,所含有的天门冬氨酸能够促进细胞免疫...










